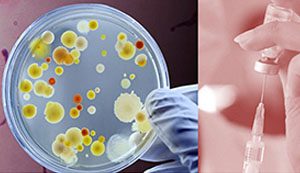

Роз’яснення щодо профілактичних щеплень та інтервалів проведення імунопрофілактики за Національним календарем
Держава забезпечує всі вакцини, які входять до Національного календаря профілактичних щеплень, а щеплення у пунктах вакцинації та медзакладах проводять безоплатно. Усе, що треба зробити, — звернутися до сімейного лікаря.
За даними Центру громадського здоров’я МОЗ України, за підсумками 2023 року 151 697 дітей отримали щеплення.
Перше щеплення проти дифтерії, правця та кашлюка роблять вакциною АКДП — полівалентною вакциною, до складу якої входять дифтерійний та правцевий анатоксини для профілактики дифтерії та правця і кашлюковий компонент для профілактики кашлюку. У цьому випадку можна використовувати вакцини як з ацелюлярним (АаКДП), так і з цільноклітинним (АКДП) кашлюковим компонентом. Це трикомпонентне щеплення допоможе сформувати імунітет одразу до трьох захворювань.
Щеплення для профілактики дифтерії, правця та кашлюку роблять за віком чотири рази: у два місяці (перше), у чотири місяці (друге), у шість місяців (третє) та у 18 місяців (четверте). Наступне щеплення, вакциною АДП, роблять у шість років — це вже ревакцинація проти дифтерії та правця, оскільки така вакцина не містить кашлюкового компонента.
Шосте щеплення роблять у 16 років вакциною АДП-М (зі зменшеним вмістом дифтерійного та правцевого антигенів). Надалі кожні десять років дорослий має оновлювати свій захист від дифтерії та правця. Для цього треба звернутися до сімейного лікаря для ревакцинації АДП-М.
Дифтерія проявляється у вигляді ангіни, під час якої в горлі утворюються плівки, що ускладнюють дихання. Вона передається повітряно-крапельним шляхом. Коли дифтерійна бактерія потрапляє в дихальну систему, вона виробляє токсин, який потрапляє до крові й вражає різні органи, найчастіше — серце, нервову систему, нирки. Для лікування від дифтерії використовується протидифтерійна сироватка та антибактеріальна терапія. Навіть попри своєчасне лікування близько 20 % хворих помирають.
Правець вражає нервову систему і проявляється сильними судомами, сильними болями у кістках, порушенням ковтання. Інфікуватися правцем можна у разі потрапляння бруду в рану або поріз, внаслідок травмування гострими предметами, уламками деревини. Наприклад, дорослий чи дитина може інфікуватися, поранившись цвяхом, через подряпини. Навіть попри екстрену реанімацію та надання швидкої медичної допомоги смертність досягає 25–80 %. Смерть, як правило, настає через спазм дихальних м’язів і параліч серцевого м’яза.
Кашлюк є дуже заразним, він легко поширюється від людини до людини повітряно-крапельним шляхом під час кашлю чи чхання Найбільш небезпечною хвороба є для немовлят, у яких вона може викликати апное — тимчасову зупинку дихання. Від кашлюку рекомендовано вакцинуватися вагітним жінкам у термін від 16 до 32 тижнів вагітності незалежно від того, чи вакцинували їх у дитинстві. Це необхідно, щоб захистити дитину від кашлюку в перші місяці її життя до отримання нею вакцини.
Хвороба починається як ГРВІ. Через 5-8 днів з’являється нападоподібний спазматичний кашель аж до почервоніння обличчя, сльозотечі, кашель має характерний свист. Напади кашлю стаються частіше вночі, ніж удень, кашель може супроводжуватись гарячкою, нежитю та іншими ознаками ГРВІ. У новонароджених і маленьких дітей замість кашлю може виникати апное — зупинка дихання генералізовані судоми. Одужання починається через 4-8 тижнів, хворий починає рідше кашляти, приступи кашлю стають слабшими. Іноді період одужання може тривати від 2 до 6 місяців.